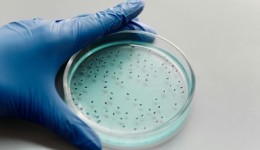
Anticoncepcional masculino injetável pode chegar ao mercado até 2028

O ministro do Desenvolvimento Agrário e Agricultura Familiar, Paulo Teixeira, disse, na noite dessa terça-feira (3), que o país está comprometido com a produção de alimentos saudáveis para garantir a soberania alimentar. A declaração foi feita na abertura da Conferência de Ministros da Agricultura das Américas, em San José, na Costa Rica. 

“Queremos, nesse encontro, conhecer as boas experiências de outros países. Queremos conhecer para dialogar com os nossos programas e ver como podemos aperfeiçoar os projetos da agricultura familiar no país. E, ao mesmo tempo, nos unir para a defesa da democracia, a diminuição da desigualdade social e a nossa capacidade de enfrentar os eventos climáticos.”
Na abertura do evento, a ministra de Mudança Climática e Meio Ambiente dos Emirados Árabes Unidos, Mariam Bint Mohammed Saeed Hareb Almheiri, defendeu que os sistemas alimentares e a atividade agropecuária sejam prioridade no combate às mudanças do clima. A participação da ministra, por mensagem gravada, se deu em razão de a próxima Conferência das Nações Unidas sobre a Mudança Climática (COP28) ocorrer em Dubai, a partir de novembro.
“Paradoxalmente, enquanto a produção agrícola aumenta globalmente, mais de 700 milhões de pessoas vão dormir com fome todos os anos e um terço da comida produzida no mundo se perde antes de chegar ao consumidor final – ou é desperdiçada”, destacou Mariam. “Nosso objetivo é trabalhar com governos e atores não governamentais, identificar inovações de alto potencial e escalá-las para que possam chegar às mãos de pequenos agricultores”, completou.
A Conferência de Ministros da Agricultura das Américas vai até esta quinta-feira (5). Temas como sustentabilidade, segurança alimentar, mudanças climáticas e agricultura familiar devem dominar os debates na capital costa-riquenha. Além de Paulo Teixeira e Mariam Bint Mohammed Saeed Hareb Almheiri, o encontro recebe ministros de todos os Estados-membros; o vencedor do prêmio Nobel de Economia Michael Kremer, e o vencedor do prêmio Mundial da Alimentação Rattan Lal.
ClicRDC